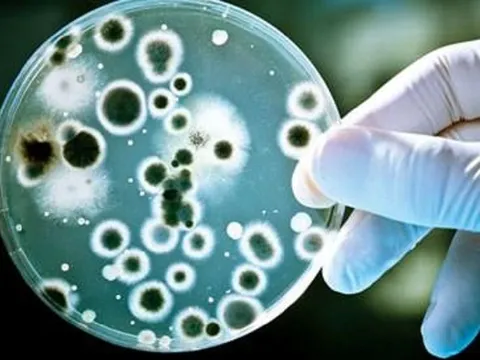
Nhiễm loại vi khuẩn kháng thuốc 'khét tiếng', nữ sinh béo phì suýt tử vong

Sức khỏe
Châu Âu bùng phát vi rút gây bệnh có thể tổn thương nội tạng
Giới chức y tế châu Âu vừa phát cảnh báo về nguy cơ du khách đến Pháp có thể nhiễm vi rút Chikungunya, một loại vi rút nguy hiểm thường thấy ở Nam Mỹ và Ấn Độ.
Giúp sản phụ bị nhau cài răng lược vượt cạn thành công
TPO - Bệnh viện Đa khoa tỉnh Quảng Trị thực hiện một ca sinh đặc biệt, giúp sản phụ bị nhau cài răng lược vượt cạn thành công.
Hà Nội sẽ hỗ trợ 100% tiền đóng bảo hiểm y tế cho những trường hợp nào?
HĐND TP Hà Nội vừa thông qua nghị quyết quy định nội dung và mức hỗ trợ đóng bảo hiểm xã hội tự nguyện, bảo hiểm y tế cho các trường hợp chính sách xã hội.
Nhiều bệnh nhân mắc sởi nhập viện: Người lớn khỏe mạnh vẫn nguy kịch vì biến chứng
TPO - Từng được xem là bệnh truyền nhiễm nhẹ, chủ yếu gặp ở trẻ nhỏ, sởi đang cho thấy một diện mạo hoàn toàn khác: lây lan nhanh, biến chứng nặng và không chừa bất kì ai, kể cả người trưởng thành khỏe mạnh.
Mỡ máu cao gấp 37 lần dù gầy gò
Tưởng mình khỏe mạnh vì thân hình nhỏ nhắn, chị N.T.H. (37 tuổi, ở Cẩm Khê, Phú Thọ) không ngờ bản thân lại rơi vào tình trạng nguy kịch vì mỡ máu cao. Dù chỉ cao 1,50m, nặng 45kg, nhưng chỉ số triglyceride trong máu của chị cao gấp 37 lần.
'Kê huyết đằng' vị thuốc quý bổ máu, chữa đau xương khớp nhưng cần sử dụng cho đúng
Gần đây trên mạng xã hội nhiều TikToker sống ở vùng cao đã khai thác và bán cây kê huyết đằng, có người gọi là cỏ máu. Đây là vị thuốc có khả năng chữa bệnh, nhưng cần kết hợp đúng cách với các dược liệu khác mới mang lại hiệu quả cao.
Ăn tiết canh, lòng heo rồi tím ngắt toàn thân phải nhập viện
Bệnh viện Bệnh nhiệt đới trung ương vừa tiếp nhận bệnh nhân nhiễm liên cầu lợn sau khi ăn tiết canh, lòng heo ở quán quen. Đây không phải trường hợp duy nhất nhiễm liên cầu lợn đang điều trị tại bệnh viện.
Từ 1/10, bệnh viện bắt buộc kê đơn thuốc điện tử: Không còn đất cho lạm dụng và kê sai
TPO - Từ ngày 1/10/2025, tất cả các bệnh viện trên cả nước bắt buộc phải thực hiện kê đơn thuốc bằng hình thức điện tử. Đối với các cơ sở khám chữa bệnh khác, thời hạn chót để thực hiện quy định này là ngày 1/1/2026. Đây là quy định tại Thông tư 26/2025/TT-BYT vừa được Bộ Y tế ban hành.
Hành trình kì diệu của người mẹ mang bệnh hiểm, đón con giữa 'bão giông'
TPO - Rạng sáng 8/7, ê-kíp 11 y bác sĩ của Bệnh viện Phụ Sản Trung ương gồm chuyên ngành phẫu thuật sản, gây mê hồi sức, sơ sinh… mang theo đầy đủ thiết bị mổ, thuốc men, máy móc hồi sức sơ sinh và lồng ấp, nhanh chóng có mặt tại Bệnh viện Phổi Trung ương…
Phẫu thuật khẩn cấp cứu cụ ông máu phun thành vòi trong bụng vì tai nạn
TPO - Trong lúc dọn nhà, ông S. bị trượt chân té cầu thang. Tai nạn xảy ra khiến nạn nhân rơi vào nguy kịch vì mất gần 2 lít máu do rách mạch máu mạc treo ruột non.
VNVC ký kết hợp tác với Nestlé Health Science nâng cao kiến thức về sức khỏe dinh dưỡng
Hệ thống tiêm chủng VNVC vừa ký kết hợp tác với Nestlé Health Science thuộc Tập đoàn Nestlé toàn cầu, chung tay nâng cao kiến thức vì sức khỏe dinh dưỡng cho cộng đồng, kịp thời mang các giải pháp dinh dưỡng khoa học và chuyên biệt hóa ở mọi lứa tuổi từ khi chào đời đến khi về già cho người dân Việt Nam.
Hướng dẫn thu hồi, xử lý thuốc vi phạm
(Chinhphu.vn) - Bộ Y tế vừa ban hành Thông tư số 30/2025/TT-BYT hướng dẫn áp dụng tiêu chuẩn chất lượng, kiểm nghiệm thuốc, nguyên liệu làm thuốc và thu hồi, xử lý thuốc vi phạm.
Nhiễm loại vi khuẩn kháng thuốc 'khét tiếng', nữ sinh béo phì suýt tử vong
TPO - Nữ sinh viên bị béo phì mức độ nặng đã rơi vào tình trạng sốc nhiễm trùng, nguy kịch tính mạng do vi khuẩn Klebsiella pneumoniae – một chủng vi khuẩn “khét tiếng” với khả năng kháng nhiều loại kháng sinh mạnh hiện nay.
"Thảnh thơi" không chỉ là mơ: Mẹ hiện đại nay đã có trợ lý thông minh ECO
Cuộc sống hiện đại với nhiều lo toan khiến việc thảnh thơi đôi khi trở thành mong ước xa tầm với. Nhưng với ECO Người Tiêu Dùng, việc sống nhẹ nhàng, an yên không còn là điều khó thực hiện. ECO mang đến một lối sống tiêu dùng thông minh, giúp mẹ vừa chăm sóc gia đình chu toàn vừa tận hưởng thời gian dành riêng cho bản thân.